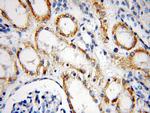
NUAK2 Antibody in Immunohistochemistry (Paraffin) (IHC (P))

Search
Proteintech
NUAK2 Polyclonal Antibody
{{$productOrderCtrl.translations['antibody.pdp.commerceCard.promotion.promotions']}}
{{$productOrderCtrl.translations['antibody.pdp.commerceCard.promotion.viewpromo']}}
{{$productOrderCtrl.translations['antibody.pdp.commerceCard.promotion.promocode']}}: {{promo.promoCode}} {{promo.promoTitle}} {{promo.promoDescription}}. {{$productOrderCtrl.translations['antibody.pdp.commerceCard.promotion.learnmore']}}
图: 1 / 10
NUAK2 Antibody (11592-1-AP) in ICC/IF

产品信息
11592-1-AP
已发表种属
宿主/亚型
分类
类型
抗原
偶联物
形式
浓度
规格
保存条件
运输条件
靶标信息
NUAK2 or SNF1/AMP kinase-related kinase (SNARK) is a member of the NUAK family of SNF1-like kinase 2. NUAK2 is activated by muscle contraction and is a unique mediator of contraction-stimulated glucose transport in skeletal muscle (1). NUAK2 is involved in cellular stress responses linked to obesity and type 2 diabetes. NUAK2 shows kinase activity against a synthetic test peptide and the activity in keratinocytes is increased by AMP and 5-amino-4-imidazolecarboxamide riboside, implying that AMPK kinase-dependent pathway can activate NAUK2. Glucose deprivation also increases NAUK2 activity in baby hamster kidney fibroblasts.
仅用于科研。不用于诊断过程。未经明确授权不得转售。



